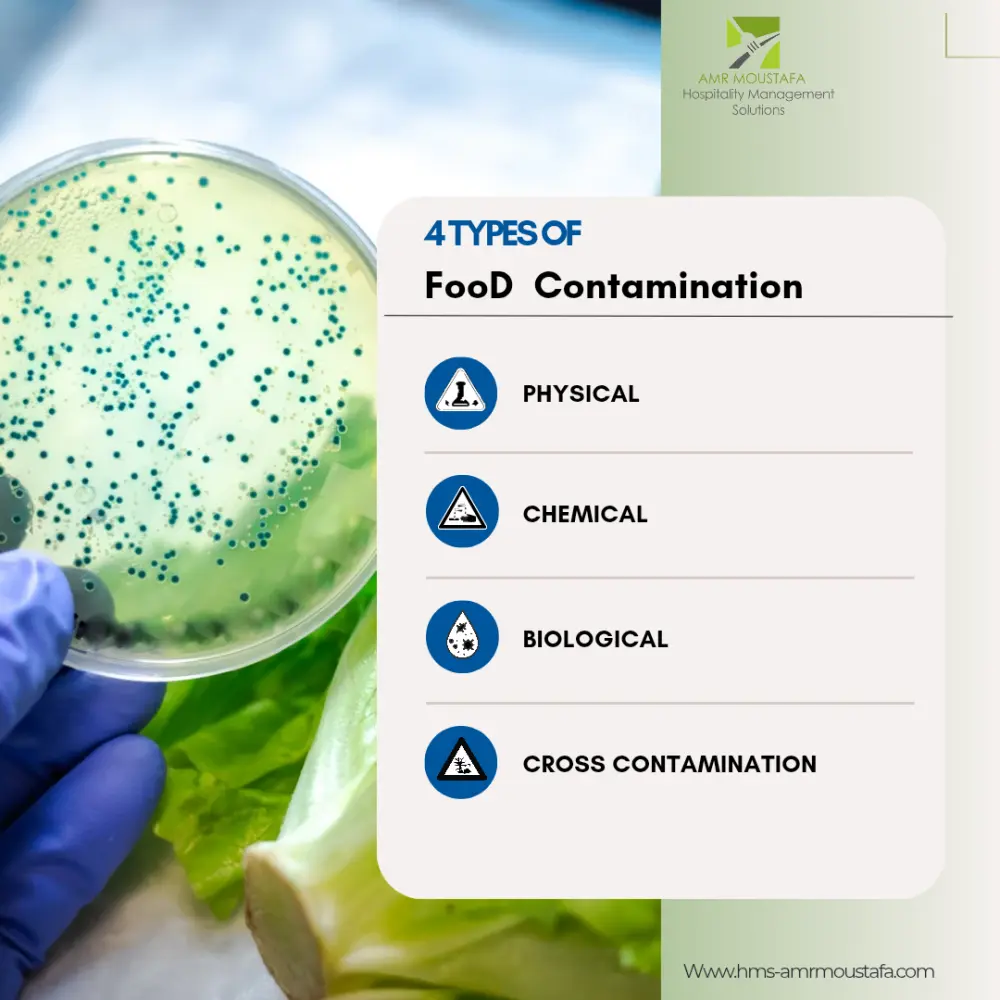
إدارة حسابات التواصل الاجتماعي باحترافية لمدة شهر

شراء الخدمة الآن
إدارة حسابات التواصل الاجتماعي باحترافية لمدة شهر
شراء الخدمة
شراء الخدمة الآن
بطاقة الخدمة
شراء الخدمة الآن